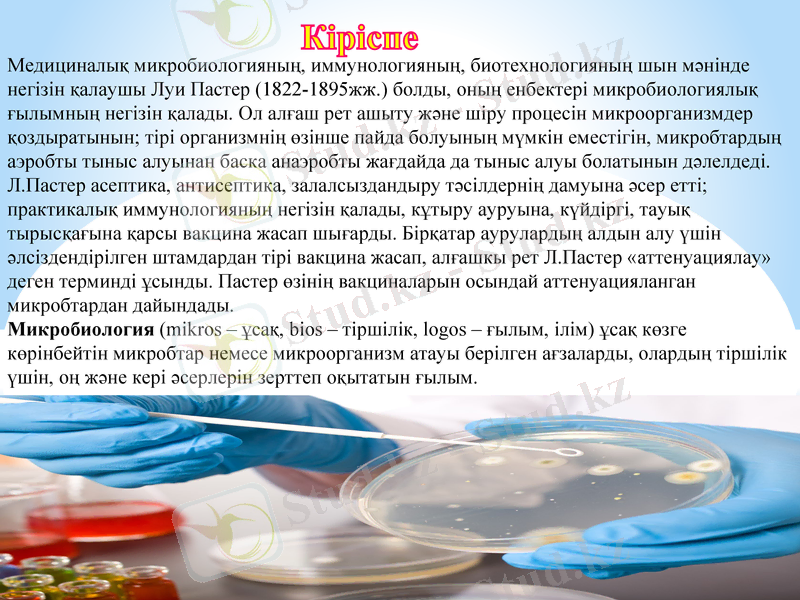
Slide 2
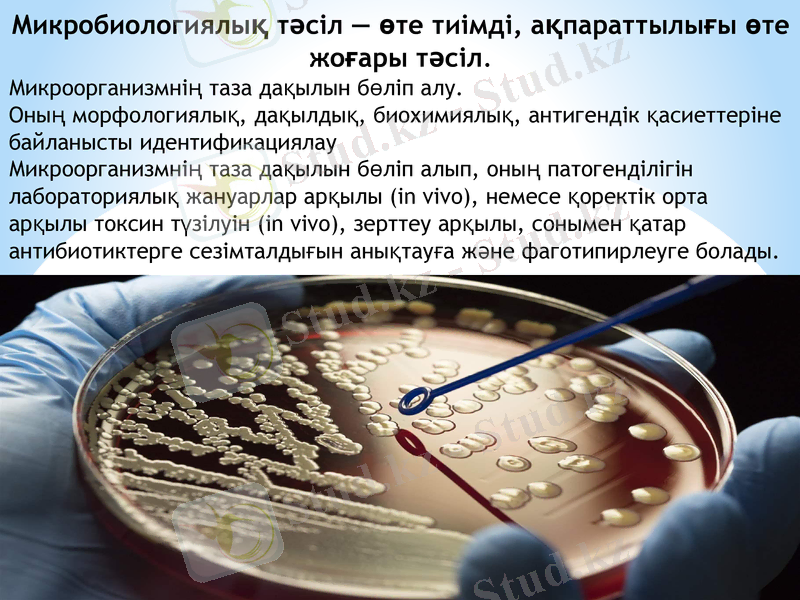
Slide 15

Медициналық микробиология және вирусология: негіздері, тарихы және зертханалық әдістері



Микробиология
және
вирусология
Медициналық микробиологияның, иммунологияның, биотехнологияның шын мәнінде негiзiн қалаушы Луи Пастер (1822-1895жж. ) болды, оның енбектері микробиологиялық ғылымның негiзiн қалады. Ол алғаш рет ашыту және шiру процесiн микроорганизмдер қоздыратынын; тірі организмнің өзiнше пайда болуының мүмкін еместігін, микробтардың аэробты тыныс алуынан баска анаэробты жағдайда да тыныс алуы болатынын дәлелдеді.
Л. Пастер асептика, антисептика, залалсыздандыру тәсілдернің дамуына әсер еттi; практикалық иммунологияның негiзiн қалады, кұтыру ауруына, күйдiргi, тауық тырысқағына қарсы вакцина жасап шығарды. Бірқатар аурулардың алдын алу үшiн әлсіздендірілген штамдардан тipi вакцина жасап, алғашкы рет Л. Пастер «аттенуациялау» деген терминдi ұсынды. Пастер өзінің вакциналарын осындай аттенуацияланган микробтардан дайындады.
Микробиология (mikros - ұсақ, bios - тіршілік, logos - ғылым, ілім) ұсақ көзге көрінбейтін микробтар немесе микроорганизм атауы берілген ағзаларды, олардың тіршілік үшін, оң және кері әсерлерін зерттеп оқытатын ғылым.
Кіріспе

Медициналық микробиология адамда ауру қоздыратын микроорганизмдерді, олардың организммен қарым-қатынасын зерттейді, жұқпалы ауруларды емдеу мен олардан алдын ала сақтандырудың лабораториялық диагностикасы және арнаулы әдістерін жасауды қарастырады. Микробиология арқылы жұқпалы аурулардың көздерін жоямыз, яғни жұқпалы аурулардың этиологиясын табу. Жаңа вакцинацияларды және қан сары суларды шығару және зертханалық диагностикаларды жақсарту. Медициналық микробиология инфекциялық аурулар қоздырғыштарының биологиялық қасиеттерін, патогендік факторларын, олардың жасушалық және молекулярлы-генетикалық деңгейде іске асырылуының механизімін зерттеп және де болашақтағы диагностика, емдеу және алдын алу тәсілдерін жетілдіреді. Микробиология ғылымы жетістіктерге жете берсе жер бетінде түрлі аурулардын алдын алуға мүмкін. Бұл ғылым өз алдында микроорганизмдерді зерттегеннен, біздің болашақ дәрігер болуымызға да көп септігін тигізеді.

Луй Пастер(1822-1895)
Микроорганизмдер XVIII ғасырдың аяғында ашыла бастаған, ал XIX ғасырдың басында ғылым ретінде қалыптасты. Микробиология негізін қалаушысы француз ғалымы, химигі және микробиологы.

Ильич Мечников(1845-1916)
Медициналық микробиологияның жетістіктерінің бірі орыс ғалымы, биолог, патолог, иммунолог және бактериолог Илья Ильич Мечников(1845-1916) еңбектерімен байланыстырады.
- Иммунология, фагоцитоз теориясын және эволюциялық эмбриологияның негізін қалаушысы - Антиденелердің пайда болу себептерін - Орыс бактериология мектебінің негізін қалаушысы - 1908 жылы гуморальды иммунитет туралы ғылымның негізін қалаған үшін Пауль Эрлих пен Илья Ильич Мечников Нобель сыйлығын ие болған

Роберт Кох (1843-1910)
Медициналық микробиология прогрессі XIX ғасырдың аяғындағы неміс ғалымы Роберт Кох (1843-1910) пен байланысты 1882 жылы наурызда Берлиндік физиологиялық ұйымда сол уақытта етек алып көп адамдардың өліміне себепші болған туберкулез қоздырғышын тапқанын жариялап микроскопта көрсеткен, соның құрметіне Кох таяқшасы деп атаған. Бір жылдан соң Египетте холлера эпидемиясы кезінде холлера эмбрионын ашқан және т. с. с медицинаға көптеген үлестерін қосқан ғалым

Вирусология - вирустар туралы ғылым
• 12 ақпан 1892 Д. И. Ивановский темекі теңбілі вирусын ашты.
Вирустар ( Vira патшалығы) - жасушасыз тіршілік құрылымы
Нуклеин қышқылының бір түрі болады ( ДНК немесе РНК) . 2. Өз бетімен ақуыз синтездей алмайды. 3. Жасушасыз құрылым . 4. Жасуша ішілік молекулалық паразиттер. 5. Белгілі бір ұлпаларға тропизм 6. Убиквитарлы. 7. НМ өлшенеді
Вирустардың химиялық құрамы:
НК (ДНК-4-40%, РНК-1-4%) -генетикалық ақпаратты тасушы Ақуыз (50-90%) -құрылымдық және құрылымдық емес ЛИПИДтер(4-42%) -вирустардың құрылысын нығайтушы Көмірсулар(3-10%) -пішінін сақтайды, протеаздан қорғайды

Иммунология - бұл ағзаның генетикалық бөгде денелерден (антигендерден) қорғану тәсілдері мен механизмдерін зерттейтін жалпы биологиялық және медициналық ғылым.

Микробиологиялық зертхана
Микробиологиялық зертхана арнайы жабдықталған, микробиологиялық бақылау көмегімен инвентарьдың, техникалық құрал - жабдықтар мен аппараттардың, қоғамдық тамақ өнеркәсібінің және тамақ өнімдерін сату жұмысшыларының санитарлық жағдайын тексереді; қоршаған орта обьектілерінің ауа, топырақ, тамақ өнімдерінің микробтармен ластануын зерттейді

Зертханалық бөлме- микробиологиялық зерттеулер жүргізуге арналған. Ол кең, жарық болуы, дезинфекция және ылғалды тазалау жүргізілуі керек. Микробиологиялық зертхана бөлмелері күнделікті ылғалды тәсілмен тазартылуы қажет. Үстел үстіндегі немесе басқа заттардағы шаңды дымқыл шүберекпен, сумен және дезинфекциялық ерітінділермен
сүрту керек.
Бокс - асептикалық жағдайда жұмыс істеуге арналған изоляцияланған бөлме. Жұмыс алдында бокс бөлмесін бактерицидтік шаммен сәулелендіреді, Жұмыс алдында қажетті
заттарды дайындап алу қажет. Себебі, жұмыс уақытында бокске кіруге немесе шығуға болмайды. Боксалды бөлмеде стерилді халат, бас киім және маска киеді. Жұмыс соңынан бокс еденін, қабырғаларды 3% - дық карбол қышқылы ерітіндісімен сүртіп және 20-30 минут бактерицидтік шаммен сәулелендіреді.
Орта пісіру бөлмесі - қоректік ортаны дайындауға, құюға, қоректік ортаны стерилдеуге және сақтауға арналған. Жуу бөлмесі - стерилдеуге арналған ыдыстарды өңдеуге және дайындауға арнайы жабдықталған бөлме. Ыдыстарды өңдеу үшін қолданылатын жуғыш заттар: сабын, кір жуу ұнтақтары, қыша, щеткалар және т. б. Автоклав бөлмесі - немесе стерилдеу бөлмесі аппараттармен жабдықталған болу керек: автоклав, кептіргіш шкаф, стерилизатор, т. б. Стерилдеу қоректік ортаны және арнайы киімді қамтиды. Зат қоймасы (материальная) - қоректік ортаны, қосымша реактивтерді, аспаптарды, аппараттарды, ыдыстарды сақтайтын бөлме.

Микробиологиялық зертханада қолданылатын негізгі Дезинфекциялайтын заттар
Дезинфекция - қоршаған ортадағы микроорганизмдерді жою.
Микроорганизмдермен күресуге арналған химиялық затты антисептиктер деп атайды. Дезинфекциялайтын заттарды келесі топтарға бөлуге болады:
1. Қышқылдар, сілтілер және олардың тұздары
ерітінділері.
2. Хлорлы заттар.
3. Ауыр металдар қосылыстары.
4. Фенол және оның туындылары
5. Газ тәрізді заттар
Газ тәрізді заттар - көптеген газдар бактерицидтік әсер туғыза алады: формальдегид, этилен қышқылы, күкірт ангидриді - пропилактон. Ауыр металл тұздары - сынап, күміс, мыс бактерицидтік әсер етеді. Олар микроорганизм нәруызына коагуляция жасайды Фенол және оның туындылары - бұл топқа көптеген фенол туындылары кіреді. Олардың ішінде микробиология практикасында карбол қышқылы және лизол қолданылады. Бұлар нәруызбен байланысқа жеңіл түседі, денатурациялайды, тіршілікке қажет функцияларды бұза отырып, біртіндеп ерігіштік әсер көрсетеді.

Микробиологиялық диагностика

Микроскопиялық тәсіл - микроорганизмнің морфологиялық, тинкториальдық қасиеттерін білдіреді.
Зерттелінетін материалдан жүғынды дайындау
оны бояу
микроскоп арқылы көру

Микробиологиялық тәсіл - өте тиімді, ақпараттылығы өте жоғары тәсіл.
Микроорганизмнің таза дақылын бөліп алу.
Оның морфологиялық, дақылдық, биохимиялық, антигендік қасиеттеріне байланысты идентификациялау
Микроорганизмнің таза дақылын бөліп алып, оның патогенділігін лабораториялық жануарлар арқылы (in vivo), немесе қоректік орта арқылы токсин түзілуін (in vivo), зерттеу арқылы, сонымен қатар антибиотиктерге сезімталдығын анықтауға және фаготипирлеуге болады.

Биологиялық тәсіл.
Биологиялық (биосынақ) тәсіл - сезімтал лабораториялық жануарлардың микроорганизмдерге сезімталдығына негізделген. Ол үшін жануарлардың жасын, салмағын, түрін ескере отырып микробтың таза дақылымен немесе алынған зерттелінетін материалдың өзімен жарақаттайды. Бұл тәсілде, жасанды қоректік ортада өспейтін патогенді микроорганизмнің таза дақылын бөліп алуға және оның патогенділігі мен вируленттілік дәрежесін анықтауға болады.


Серологиялық диагностикада науқас адамның қан сарысуында арнайы антиденелердің түзілуі мен ауру барысында жиналуына негізделінген.
Тері-аллергиялық сынақ кейбір инфекциялық ауруларды (туберкулез, бруцеллез, туляремия) зерттегенде ағзаның антигендерге жоғары сезімталдығын анықтау мақсатында қолданады.

Бактериоскопиялық зерттеу
Бактериологиялық, вирусологиялық зерттеулер инфекциялық аурулардан қайтыс болғандарға қорытынды диагноз қоюда маңызды. Бұл әдістер инфекциялық аурулардың эпидемиологиялық өршуі мен клинико-эпидемиологиялық мәліметтердің жеткіліксіздігінде, нақты әрі тез эпидемияға қарсы шаралар диагностикасы қажет уақытта қолданылады.
Инфекциялық аурулардан өлген мәйітті жару барысында патологанатомнан басқа дәрігер инфекционист, бактерилог-маман қатысуы қажет, олар мәйіттен қажет бактерилогиялық, вирусологиялық материалдар алып, секционды столда сәйкес ортаға егу жүргізеді.

Бактериоскопиялық әдіс көптеген мемлекеттерде диагностика үшін ғана емес, сол сияқты туберкулезді анықтау үшін тексергенде қолданады.
Бактериоскопиялық әдістің артықшылығы: белгілі мақсатта қауіпті топ өкілдеріне жүргізіледі, нәтижесі дәл, арзан, ыңғайлы, ағзаға зияны жоқ.
Бактериоскопиялық тексеріс жүргізудің әдістемесі
Зертханаға жіберуге арналған қақырық саңылаусыз жабылатын бұрандамалы қақпағы бар, қонтейнерлерге (түкіргіштерге) жиналады, олар қажетті шамада жуылып дезинфекцияланғаннан кейін бірнеше рет пайдаланылады. Бір рет қана қолданылатын түкіргіштер пайдаланылғаннан кейін енді іске жаратылмайды, жойылады. Түкіргіштің сыртына науқастың аты-жөні, туған жылы, қақырық жиналған күні, идентификациялық реттік саны жазылған этикетка жапсырылады. Әр сынамаға жолдама жазылады - 05 ТБ формасы.
Бактериоскопия әдісіне Циль-Нильсен бойынша бояу, флотация және люминисцентті микроскопия әдістері жатады.

Бактериологиялық зерттеу әдісі бактериоскопиялық әдіспен ерекшеленеді. Біріншісінде талдау үшін арнайы дайындалған тірі прокариоттар мәдениеті қолданылады, ал екіншісінде шыны слайдтағы өлі немесе тірі жасушалармен жұмыс жүргізіледі.
Бактерия дақылының қасиеттерін зерттеу принципі прокариотты жасушаларды зерттеуді мақсат етіп қойған микробиологтар үшін де, міндеті бактериялардың патогенділігін немесе патогенді еместігін анықтау, содан кейін науқасқа диагноз қою болып табылатын лаборанттар үшін де пайдалы болуы мүмкін.
Бактерияларды зерттеу әдісі үш кезеңге бөлінеді:
1. Бастапқы сынамадан бактерияларды бөліп алу.
2. Бактерияларды егу және таза дақыл өсіру, оның қасиеттерін зерттеу.
3. Бактерия жасушаларын егжей-тегжейлі зерттеу.

Қорытынды
- Іс жүргізу
- Автоматтандыру, Техника
- Алғашқы әскери дайындық
- Астрономия
- Ауыл шаруашылығы
- Банк ісі
- Бизнесті бағалау
- Биология
- Бухгалтерлік іс
- Валеология
- Ветеринария
- География
- Геология, Геофизика, Геодезия
- Дін
- Ет, сүт, шарап өнімдері
- Жалпы тарих
- Жер кадастрі, Жылжымайтын мүлік
- Журналистика
- Информатика
- Кеден ісі
- Маркетинг
- Математика, Геометрия
- Медицина
- Мемлекеттік басқару
- Менеджмент
- Мұнай, Газ
- Мұрағат ісі
- Мәдениеттану
- ОБЖ (Основы безопасности жизнедеятельности)
- Педагогика
- Полиграфия
- Психология
- Салық
- Саясаттану
- Сақтандыру
- Сертификаттау, стандарттау
- Социология, Демография
- Спорт
- Статистика
- Тілтану, Филология
- Тарихи тұлғалар
- Тау-кен ісі
- Транспорт
- Туризм
- Физика
- Философия
- Халықаралық қатынастар
- Химия
- Экология, Қоршаған ортаны қорғау
- Экономика
- Экономикалық география
- Электротехника
- Қазақстан тарихы
- Қаржы
- Құрылыс
- Құқық, Криминалистика
- Әдебиет
- Өнер, музыка
- Өнеркәсіп, Өндіріс
Қазақ тілінде жазылған рефераттар, курстық жұмыстар, дипломдық жұмыстар бойынша біздің қор #1 болып табылады.



Ақпарат
Қосымша
Email: info@stud.kz